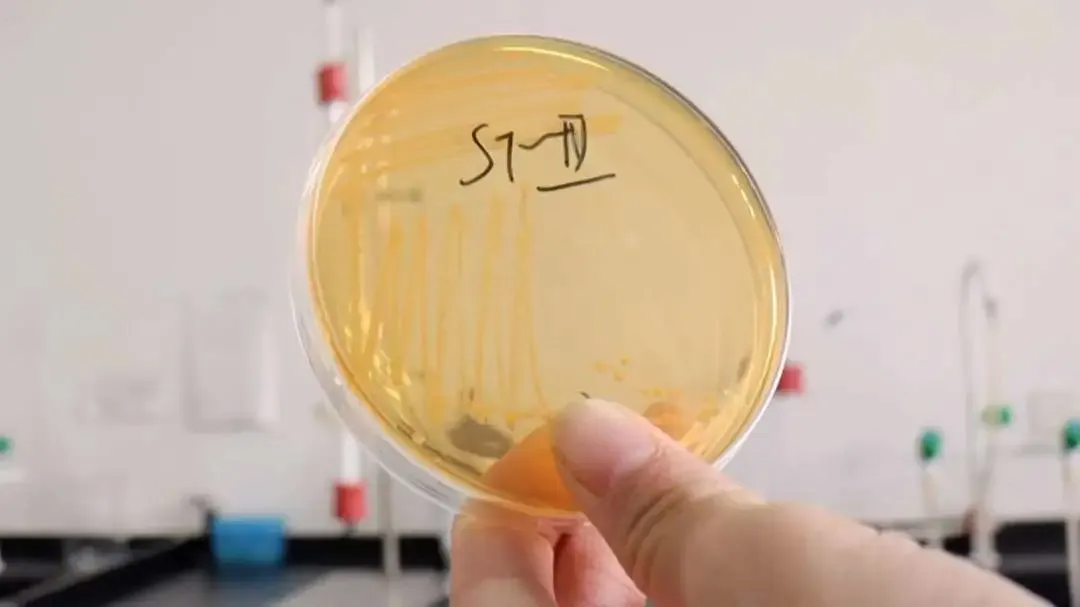

来源 :光明乳业2025-06-26
儿童孤独症关爱行动
走近TA们的“孤独星球”
在这个世界上,有一群独特而美好的“星星的孩子”。他们有着纯真的心灵和独特的感知方式,需要我们用更多的耐心、理解与爱去靠近、去守护。光明乳业始终心系每一位孩子的健康成长,特别关注这些“星星的孩子”及其家庭的需要。为了探索更多可能的方式帮助“星星的孩子”,光明乳业携手上海市儿童医院消化感染科和上海市生物医药技术研究院,共同启动「植物乳植杆菌ST-Ⅲ与儿童孤独症谱系障碍的前瞻性关爱研究」,并面向全社会开放招募适龄儿童伙伴。


植物乳植杆菌ST-Ⅲ
全新的健康选择
植物乳植杆菌ST-Ⅲ,源于中国南方地区传统发酵泡菜。作为一种优秀的益生菌,植物乳植杆菌ST-Ⅲ以其独特的生理功能和广泛的应用前景,逐渐受到科研人员和市场的关注。多年来,光明乳业研究院致力于该菌株的有益功能研究。
前期研究发现,植物乳植杆菌ST-Ⅲ能够改善血脂和胆固醇水平,调节体外模拟的婴儿肠道菌群,并改善孤独症模型动物的肠道菌群和行为障碍。
经过严格研发和评测,植物乳植杆菌ST-Ⅲ不仅在2009年被国家卫生部批准为新资源食品,并长期在光明乳业多款酸奶和发酵乳产品中使用,为消费者提供了全新的健康选择。

?
?
光明益菌多小蓝瓶
风味发酵乳
?
?
特别添加植物乳植杆菌ST-Ⅲ,5菌优选配比,活性乳杆菌数量高达1000亿,在肠道存活率超高,为身体注入自然活力,7天连续饮用,为日常带来满满“菌”衡力。
点击图片选购
?
?
光明畅优原味发酵乳
?
?
植物乳植杆菌ST-Ⅲ开启4菌活力协助,从肠道开始守护身体的活力状态,安抚肠道的“小情绪”,同时每杯含有3g原生乳蛋白,日常饮用,健康轻盈。
点击图片选购


植物乳植杆菌ST-Ⅲ
与儿童孤独症谱系障碍的前瞻性关爱研究
报名通道现已开启
符合以下条件的小伙伴
即可报名参与研究成为受试者
01
已诊断儿童孤独症谱系障碍
02
年龄小于18岁
03
无明确脑外伤、脑瘫、脑炎等
脑部器质性疾病
04
无消化道等其它系统严重疾病
合格入选的受试者
将获得免费提供的
植物乳植杆菌ST-Ⅲ菌粉
扫描二维码报名参加
走近“星星的孩子”
用理解与爱拥抱他们的世界

光明乳业期待与您携手同行
为每一颗“星星”点亮温暖之光!
未来,光明乳业将持续携手专业力量,深化科研探索,普及科学认知,致力于将研究成果转化为切实的关怀行动,长久守护“星星的孩子”健康成长,点亮每一份独特的微光。